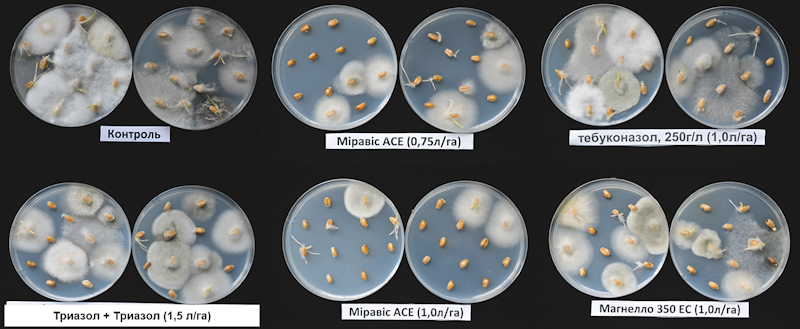

Підвищення ефективності рослинництва тісно пов’язано з упровадженням сучасних технологій вирощування. Важливою складовою останніх у рослинництві України є використання високотехнологічних продуктів вітчизняного виробництва та провідних країн світу. Проте економічні, соціальні та політичні обмеження стримують упровадження сучасних високоефективних засобів захисту рослин.
Останні роки спостерігається різке погіршення й фітосанітарного стану посівів зернових культур через нехтування сівозміною, недотримання рекомендацій застосування ЗЗР та їхніх норм і строків унесення, резистентність і низку інших причин. Зокрема, найбільш загрозливою є ситуація зі зростанням шкодочинності хвороб, що безпосередньо впливає на врожай, його валовий збір і якість. Найдинамічніше прогресують такі хвороби, як гельмінтоспоріози, септоріоз, піренофороз, альтернаріоз, борошниста роса, сажкові хвороби та фузаріози.
Фузаріоз колоса є одним із найшкідливіших хвороб зернових колосових культур. Значна поширеність, зв’язок із ґрунтом, відсутність вузької спеціалізації в ураженні рослин-господарів, потужні міграційні процеси інокулюму на значній відстані — все це зумовлює постійну наявність в агрофітоценозах культурних рослин численних грибів різних видів Fusarium, що є збудниками кореневих гнилей і хвороб вегетативних і генеративних органів рослин. За багаторічними даними від ураження фузаріозами недобір урожаю зернових колосових культур може досягати від 5 до 15% щорічно, а в умовах епіфітотії, які на теренах нашої держави спостерігаються кожні 3–5 років, втрати врожаю на окремих полях можуть перевищувати 50%. До того ж забруднене мікотоксинами збіжжя робить урожай непридатним до споживання.
Варто також зазначити, що згідно з ДСТУ 3768:2019, уражених фузаріозом зерен не повинно бути більше ніж 0,3–1,0%, залежно від класу зерна. Слід розрізняти інфіковане та уражене зерно.
Уражене зерно — це коли грибниця проникає у саме зерно, в його алейроновий прошарок, руйнуючи білки з виділенням NH₃ та накопиченням токсинів. Зерно, уражене Fusarium spp., нерідко щупле й втрачає посівні якості. Хліб, випечений із цього зерна, отруйний і колись мав назву «п’яний хліб». Корми, виготовленні з ураженого токсинами зерна, можуть призвести до захворювань свійських тварин.
Інфіковане насіння — це коли грибниця знаходиться в оболонці зерна або перикарпі. У цьому разі не спостерігається таких важких наслідків, але з досить високою імовірністю можна очікувати ураження кореневими гнилями.
Ми всі звикли до загального поняття «фузаріоз», проте щодо цієї хвороби такий підхід є досить спрощеним, бо прояви фузаріозів можуть бути різноманітними: у вигляді кореневих гнилей, фузаріозу листків або колоса, снігової плісняви та ін. Причому ці прояви та їх спосіб вираження залежать від виду грибів. Наприклад, Fusarium culmorum — джерело снігової плісняви, а Fusarium sporotrichioides — одна з причин фузаріозу колоса. Щодо фузаріозу колоса, то за загальною назвою зерно може суттєво відрізнятись за типами токсинів, бо різні види Fusarium продукують численні мікотоксини. Тому розуміння, якими саме видами уражено рослини або зерно, є дуже важливим для з’ясування типу загрози для вирощування зернових культур.
Слід зауважити, що фузаріозні гриби по-різному реагують на вологу та температуру. Так, Fusarium culmorum потребує холодних і вологих умов, Fusarium graminearum — тепла та вологи, а Fusarium langsethiae і F. poae добре розвиваються в теплих умовах і за помірної вологи.
.jpg)
Таким чином, залежно від погодних умов можна очікувати розвитку тих чи інших видів збудників Fusarium, однак у будь-якому разі вони будуть на вегетативних і генеративних органах культурних рослин і продукуватимуть небезпечні мікотоксини. Саме тому контроль фузаріозу колоса має бути обов’язковим елементом захисту, як і протруювання насіння.
Мікотоксини ((mykes, mukos) «гриб» та (toxikon) «отрута») — це вторинні метаболіти, які виробляють організми царства гриби. Зазвичай під терміном мікотоксини мають на увазі токсичні сполуки, що їх виробляють гриби, які уражують сільськогосподарські культури, зокрема збіжжя. Один вид грибів може виробляти кілька мікотокснинів, так само як і кілька видів можуть виробляти той самий мікотоксин.
Мікотоксини не лише знижують цінність зібраного врожаю, а й спричинюють захворювання домашніх тварин і птиці, що зумовлює зниження продуктивних показників. Мікотоксини біосинтезують гриби роду Aspergillus, Fusarium, Penicillium, Claviceps, Stachybotrys, Rhizoctonia. Вони формуються протягом періоду росту грибів на зерні в полі, під час збирання, зберігання й після переробки в умовах, сприятливих для росту грибів. Наприклад, у південних і центральних регіонах Європи переважно поширені фузаріотоксини.
Шкідливість грибів Fusarium graminearum, F. sporotrichiella Bilai (разом із грибами Trichoderma spp. і Trichothecium spp. та ін.) проявляється в продукуванні трихотеценів, які об’єднують понад 180 мікотоксинів чотирьох типів, найнебезпечнішими з яких є: Т-2 токсин, диацетоксискирпенол (тип А); дезоксиніваленол (ДОН), ніваленол (тип В); роридин (тип С) і кротоцин (тип D). Найпоширенішим трихотеценом є ДОН (вомітоксин), а найнебезпечнішим Т-2 токсин.
Усі прекрасно розуміють, що для ефективного контролю фузаріозу в усьому світі та Україні потрібно використовувати три діючі речовини: тебуконазол, метконазол і протіоконазол. Ці д. р. є в багатьох препаратах і мають різну ефективність, проте у всіх цих препаратах та д. р. є спільний недолік — це недостатньо ефективний контроль Т-2 мікотоксинів. У 2022 році в Україні було зареєстровано препарат Міравіс® Ейс, який уже з 2023 року буде доступним для українських аграріїв.
Фото 1. Загальний вигляд зразків, закладених на живильне середовище для пророщування
Дослідження, що проводять по всьому світі, а також в Україні, демонструють його відмінну ефективність у контролі видів Fusarium і збільшенні врожайності зернових культур, що і можна спостерігати на графіках і в таблицях, наведених нижче.
Таблиця 1. Назви основних мікотоксинів, що продукуються видами Fusarium

Таблиця 2. Найважливіші види Fusarium, що інфікують зернові культури, та основні мікотоксини, які вони продукують

Таблиця 3. Збудники та мікотоксини світового значення

Ознайомившись із результатами досліджень, таблицями та графіками, які надано вище, можна дійти таких висновків:
• діючі речовини мають різну ефективність у контролі фузаріозу (рис. 1) і різниця в ефективності становить від 20 до 40%, а найвищий рівень контролю спостерігається в Адепідин™ — 75–85%;
• як видно з рис. 2, найвищий рівень захисту виявлено за застосування фунгіцидів у фазу ВВСН 59–61 (початок цвітіння);
• на рис. 3 (уміст мікотоксинів Т-2 токсин) чітко видно, що тільки Міравіс® Ейс демонструє достатній контроль мікотоксинів, особливо Т-2 токсину;
• збільшення врожайності (рис. 4), яку зафіксовано за застосування наявних на ринку препаратів, становить за внесення у Т3 (ВВСН 59–61) 3–4 ц/га, тим часом як за застосування Міравіс® Ейс урожайність збільшилась на 11–12 ц/га.
Таблиця 4. Максимально допустимий уміст мікотоксинів у зерні пшениці

Таблиця 5. Описання продукту Міравіс® Ейс

Таблиця 6. Застосування Міравіс® Ейс

Головні переваги Міравіс® Ейс
• Міравіс® Ейс — унікальний SDHI фунгіцид, що містить Адепідин™ і забезпечує новий потужний механізм захисту від фузаріозу;
• найширший спектр захисту колоса й унікальна ефективність у контролі фузаріозів, альтернаріозу, плямистостей і септоріозів;
• відмінна стратегія боротьби з резистентністю;
• ефективний контроль мікотоксинів (особливо Т-2 токсину);
• містить два різні механізми дії на збудника хвороби;
• рівномірне розподілення у восках і рослині для оптимального захисту протягом тривалого часу;
• висока фотостабільність і стійкість до змивання дощем.


Рис. 1. У чому унікальність Адепідин ™ для зернових культур
Таблиця 7. Адепідин™ — унікальна ефективність щодо Fusarium spp.
Новий спосіб дії для боротьби з широким спектром видів фузаріозу

З описаного вище можна дійти висновку, що саме Міравіс® Ейс є препаратом для ефективного захисту від хвороб колоса зернових культур, зокрема і видів Fusarium, що є важливою складовою досягнення високої продуктивності, якості та рентабельності агровиробництва. Слід зазначити, що дослідження з Міравіс® Ейс і досі тривають у численних лабораторіях і польових станціях по всьому світі. Щодо встановлених розбіжностей в ефективності Міравіс® Ейс, порівнюючи з різними препаратами та діючими речовинами, можна констатувати високу ефективність, безпеку використання, гнучкість застосування, а також чітко виражений позитивний фізіологічний вплив на посіви, врожай і його якість. Безперечно, Міравіс® Ейс є одним із можливих елементів підвищення врожайності зернових культур в Україні.

Рис. 1. Фузаріоз колоса (Fusarium Spp.) пшениці. Новий рівень контролю хвороби (Ефективність (%), ступінь ураження на контролі — 53% у 2017 р., 40% — у 2018 р. та 47% — у 2019 р.)
Джерело: Штайн-Дженніфер Марк і Стефан Бірі

Рис. 2. Фузаріоз колоса (Fusarium Spp.) пшениці. Новий рівень контролю хвороби. (Ефективність (%) залежно від фази внесення, ступінь ураження на контролі 72 %)
Рис. 3. Уміст мікотоксинів — Т-2 токсин (Т-2) (Максимально допустимий уміст — 0,1 мг/кг)
Рис. 4. Урожайність, т/га
Станіслав ГОРПИНЮК, менеджер із технічної підтримки
фунгіцидів на зернових культурах компанія «Сингента»





